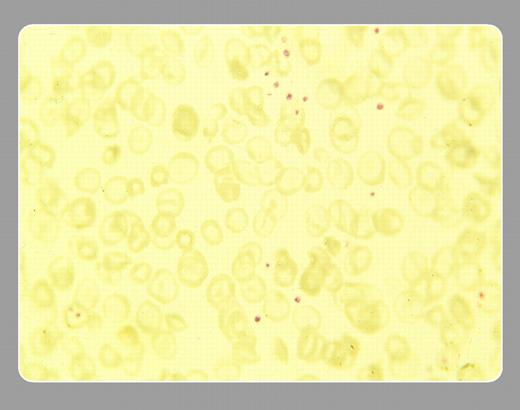
Stanley Schrier, Stanford University School of Medicine

Note the profound red blood cell hypochromia, target cells, and small fragments. For unclear reasons, double heterozygosity for 2 clinically mild conditions leads to a variable clinical picture, with hemoglobin values ranging from 3.5 g/dL to 13 g/dL but frequently with a severity like that of β thalassemia major.
Copyright © 2003 by The American Society of Hematology
2003
Stanley Schrier, Stanford University School of Medicine